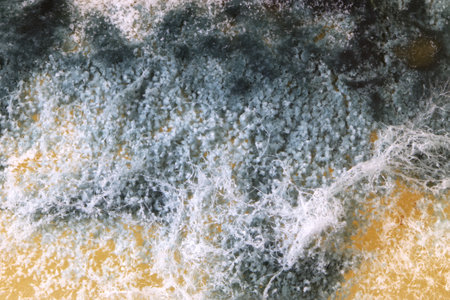
Microscopic view of mold on cheese, hard cheese with white and black mold on it. Moldy fungus on foodの写真素材

写真素材 - Microscopic view of mold on cheese, hard cheese with white and black mold on it. Moldy fungus on food
作品情報
Microscopic view of mold on cheese, hard cheese with white and black mold on it. Moldy fungus on food
- ID:242528999
- 作品種別:写真
- 作者名:Peter Jurik
キーワード
- age
- bacterium
- biology
- biotechnology
- black
- cheese
- close-up
- closeup
- colony
- dairy
- danger
- different
- dirty
- discovery
- education
- food
- fungal
- fungus
- growth
- hard
- health
- health-care
- healthcare
- hygiene
- illness
- macro
- medical
- medicine
- micro
- microbiology
- microorganism
- microscope
- mold
- moldy
- mould
- no people
- nobody
- old
- process
- product
- research
- rotten
- science
- smell
- spoil
- spoiled
- spore
- stink
- surface
- unhealthy
類似作品
A detailed view...
Artistic macro ...
Bright yellow c...
Cheese with smo...
Cheese with smo...
Abstract blue c...
An extreme clos...
spread of green...
A close-up reve...
Close up textur...
Close-up view o...
microbiology ba...
Yellow christma...
Mold growth is ...
close up view o...
This close-up v...
Close-up view r...
Abstract blue c...
Close up view r...
Close up textur...
Macro shot of a...
Microscopic Fun...
The patterns an...
Close examinati...
Close-up of a y...
Backgrounds of ...
abstract cellul...
Swiss cheese cl...
The surface of ...
Abstract blue c...
A close up of a...
spread of green...
Mold. Nice mold...
microscopic vie...
Osteoclasts are...
Backgrounds of ...
Mold on pork ca...
development of ...
Close-up of yel...
A detailed view...
A close-up view...
Yellow swiss ch...
The texture of ...
Backgrounds of ...
This colorful m...
Cheese with smo...
Abstract blue c...
A close-up view...
close-up of bac...